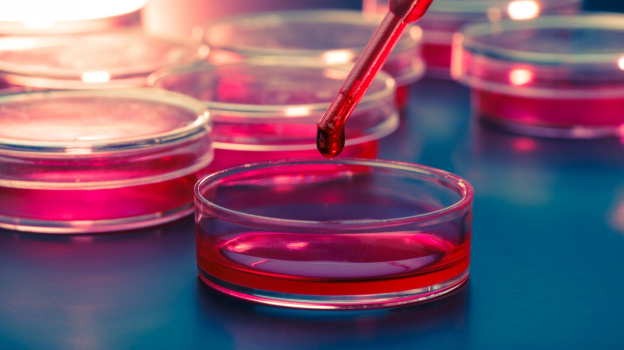
Cell Culture Market

The global cell culture market is poised for significant growth, with projections estimating a rise from USD 27,911.3 million in 2024 to USD 44,593.1 million by 2034. According to the latest analysis by Future Market Insights (FMI), the market is expected to grow at a compound annual growth rate (CAGR) of 4.7% from 2024 to 2034. This expansion will be driven by several key factors, including the escalating demand for biopharmaceuticals, advancements in stem cell culture techniques, and the growing emphasis on personalized medicine.
Cell culture technology is becoming indispensable in the production of crucial biopharmaceuticals such as monoclonal antibodies, insulin, and vaccines. With the rise in chronic diseases globally, the demand for these biopharmaceuticals is set to propel the global need for cell culture systems. This trend is expected to continue as healthcare systems seek innovative solutions to address widespread health issues.
In addition to biopharmaceutical production, the rapidly expanding field of personalized medicine is contributing significantly to the growth of the cell culture market. Personalized medicine, which tailors medical treatment based on an individual’s genetic profile, is transforming drug development and disease management. Researchers are now utilizing cell culture to create complex, customized disease models based on patients’ cells, enabling a more accurate analysis of genetic makeup. This precision in drug testing improves treatment outcomes, reduces side effects, and increases the chances of successful therapies.
Furthermore, the increasing demand for vaccines and growing healthcare awareness are expected to support steady market growth. Government initiatives, such as India’s “Nishank” Drug Discovery Hackathon launched in July 2020, are also fostering drug discovery and innovation, further driving the demand for advanced cell culture techniques.
Research into personalized medicine continues to intensify, with oncology emerging as one of the most lucrative areas due to disease heterogeneity and the rising number of approved biomarkers. Immunology and neurodegenerative diseases are also receiving considerable attention from pharmaceutical and biopharma companies, highlighting the pivotal role of cell culture in advancing these fields.
As personalized medicine becomes a cornerstone of modern healthcare, the cell culture market is set to benefit from its integral role in this transformative sector. The market’s growth reflects a broader trend toward precision medicine, with cell culture playing a critical role in driving innovation, improving drug development, and enhancing patient outcomes.
Key Takeaways from the Market Study:
- The global market value is estimated to total USD 44,593.1 million in 2034.
- By phase, the commercial segment is projected to lead the market, growing at a CAGR of 3.9% during the forecast period.
- By end user, the biotechnology and pharmaceutical companies segment is set to grow at 6.0% CAGR through 2034.
- North America accounted for a prominent value share of 36.8% in 2023.
- The United States is set to record a CAGR of 3.0% through 2034.
- Revenue in China is poised to rise at 7.9% CAGR between 2024 and 2034.
“Researchers and biotechnologists are adopting sustainable and animal-free cell culture technologies. This transition aims to reduce reliance on animal-derived products and mitigate the environmental impact of cell culture processes.” – says a lead analyst of Future Market Insights (FMI).
Increased Market Attention: Delve into Detailed Trends and Analysis with Our Report!
Who is Winning?
Leading companies are implementing tactical approaches, such as mergers and acquisitions, business extensions, and new product creation, in order to broaden their range of offerings and fortify their position in the market. For instance,
- In July 2023, With GS-CHO cell lines, Lonza introduced the TheraPRO CHO Media System, a new platform for cell culture that streamlines procedures and maximizes output and protein quality.
- In June 2021, Bio-Rad Laboratories, Inc. collaborated with Seegene, Inc. for the clinical development and commercialization of molecular diagnostic tools for infectious diseases.
Key Companies Profiled:
- Thermo Fisher Scientific Inc.
- Merck KGaA (Sigma-Aldrich Co., LLC).
- Danaher Corporation (Cepheid)
- Agilent Technologies, Inc.
- Bio-Rad Laboratories
- STEMCELL Technologies
- Lonza AG
- Corning Incorporated
- Eppendorf AG
- FUJIFILM Irvine Scientific, Inc.
- Sartorius AG
- Getinge AB
- HiMedia Laboratories
- Cellexus
- Biospherix Ltd.
- PromoCell GmbH
- Bio-Techne Corporation
Key Market Segments:
By Product:
- Consumables
- Media
- Serum Containing Media
- Serum Free Media
- Protein Expression Media
- Stem Cell Media
- Hybridoma Media
- Primary Cell Media
- Insect Cell Media
- Immunology Media
- CHO Cell Culture Media
- HEK Media
- BHK Media
- Protein Free Media
- Chemically Defined Media
- Sera
- Fetal Bovine Sera (FBS)
- Adult Bovine Sera (ABS)
- Other Animal Sera
- Reagents
- Growth Factors
- Supplements
- Buffers & Chemicals
- Cell Dissociation Reagents
- Cryoprotective Agents
- Other Reagents
- Media
- Cell Lines
- CHO
- HEK
- Stem Cells
- Hematopoietic (Blood-Forming) Stem Cells (HSC)
- Skeletal Muscle Stem Cells
- Mesenchymal Stem Cells
- iPSCs
- Lymphocytes
- Dendritic Cells
- Pancreatic Islet Cells
- CAR-T Cells
- Equipment
- Supporting Equipment
- Filtration Systems
- Cell Counters
- Carbon Dioxide Incubators
- Centrifuges
- Autoclaves
- Microscopes
- Biosafety Cabinets
- Other Supporting Equipment
- Bioreactors
- Static Culture system
- Hollow Fiber Bioreactor System
- Stirred Bioreactor Systems
- Perfusion Bioreactor Systems
- Microcarrier Based Systems
- Suspension Culture Systems
- Storage Equipment
- Refrigerators & freezers
- Cryostorage Systems
- Other Equipment
- Cell Isolation System
- Automated Cell Processing Systems
- Cryopreservation Systems
- Cell Characterization & analysis systems
- Automated Filling & Packaging Systems
- Automated Liquid Handing Systems
- Supporting Equipment
- Cultureware
- Vessels
- Roller/Roux Bottles
- Cell Stacks
- Multiwell Plates
- Flasks
- Petri Dishes
- Accessories
- Vessels
By Application:
- Cell Therapy
- Gene therapy
- Protein Production
- Other Applications
By Phase:
- Clinical/Research & Development
- Research
- Pre-Clinical
- Clinical
- Commercial
By End User:
- Biotechnology and Pharmaceutical Companies
- Contract Research Development & Manufacturing Organizations (CDMO)
- Contract Research Organizations (CROs)
- Academic and Research Institutions
By Region:
- North America
- Latin America
- East Asia
- South Asia and Pacific
- Western Europe
- Eastern Europe
- Middle East and Africa
About Future Market Insights (FMI)
Future Market Insights, Inc. (ESOMAR certified, recipient of the Stevie Award, and a member of the Greater New York Chamber of Commerce) offers profound insights into the driving factors that are boosting demand in the market. FMI stands as the leading global provider of market intelligence, advisory services, consulting, and events for the Packaging, Food and Beverage, Consumer Technology, Healthcare, Industrial, and Chemicals markets. With a vast team of over 400 analysts worldwide, FMI provides global, regional, and local expertise on diverse domains and industry trends across more than 110 countries.
Contact Us:
Future Market Insights Inc.
Christiana Corporate, 200 Continental Drive,
Suite 401, Newark, Delaware – 19713, USA
T: +1-347-918-3531
For Sales Enquiries: sales@futuremarketinsights.com
Website: https://www.futuremarketinsights.com
LinkedIn| Twitter| Blogs | YouTube